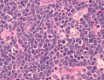

Epstein-Barr virus and Burkitt's lymphoma. Associations in Iraqi Kurdistan and twenty-two countries assessed in the International Incidence of Childhood Cancer
- PMID: 35897021
- PMCID: PMC9327396
- DOI: 10.1186/s13027-022-00452-0
Epstein-Barr virus and Burkitt's lymphoma. Associations in Iraqi Kurdistan and twenty-two countries assessed in the International Incidence of Childhood Cancer
Abstract
Background: Burkitt's lymphoma (BL) has worldwide variations in incidence that are related to the age of Epstein-Barr virus (EBV) infection. This study examined the age-specific incidence rate (ASIR) of BL and community EBV seropositivity in Iraqi Kurdistan and compared results with data from countries tabulated in the International Incidence of Childhood Cancer volume 3 (IICC-3). VSports手机版.
Methods: The ASIR (95% confidence intervals) of BL in Sulaimani Governorate of Iraqi Kurdistan were calculated for the years 2010-2020. Specimens from 515 outpatients were tested for IgG and IgM antibodies to EBV viral capsid antigen. V体育安卓版.
Results: In Sulaimani, 84% of BL occurred under 20 years of age, with an ASIR of 6. 2 (4. 7-7. 7) per million children. This ASIR was not significantly different than that of Egypt, Morocco, Israel, Spain, or France. It was slightly higher than the ASIR of the United States, the United Kingdom, and Germany and markedly higher than for Asia and South Africa V体育ios版. In Africa and much of Asia, early childhood EBV exposure predominates, with nearly all children being infected by 5 years of age. In Sulaimani, just over 50% of children were EBV seropositive at 3 years old and 90% seropositivity was reached at 15 years of age. In Europe and North America, seropositivity is commonly delayed until adolescence or young adulthood and adult predominates over childhood BL. .
Conclusion: In the Middle East, childhood BL is relatively common and adult BL is rare. In Sulaimani, EBV seropositivity increases progressively throughout childhood and reaches 92% at mid-adolescence. This may reflect the Mid East more widely. We suggest that the high childhood and low adult BL rates may be a regional effect of a pattern of EBV exposure intermediate between early childhood and adolescent and young adult infections VSports最新版本. .
Keywords: Burkitt's lymphoma; EBV seropositivity; Epstein-Barr virus; Middle East; Pediatric lymphoma. V体育平台登录.
© 2022. The Author(s).
Conflict of interest statement
The authors declare no conflict of interest. The manuscript has not been previously published in whole or in part VSports注册入口.
Figures
References
LinkOut - more resources
Full Text Sources